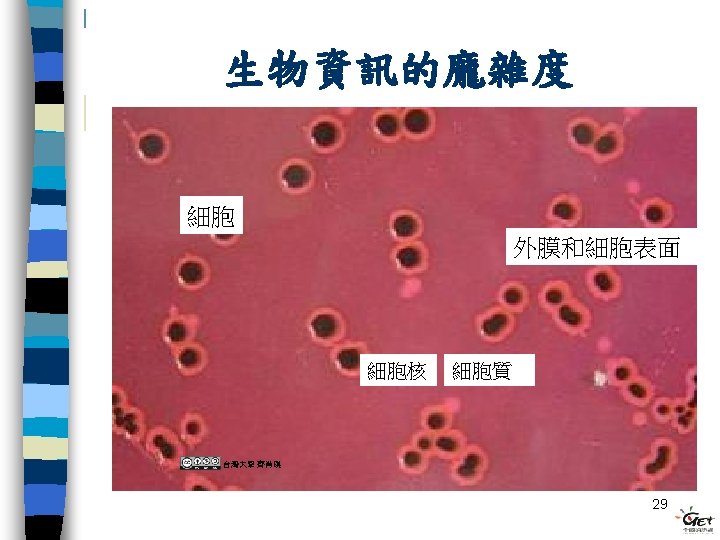

10 Flickr DArcy Norman Wiki Arnaud Gaillard Flickr

- Slides: 51
10 Flickr D'Arcy Norman
攝取能量並轉換能量 Wiki Arnaud Gaillard Flickr tinken 16
會對環境的刺激有反應 Wiki che 捕蠅草 Flickr robotpolisher 狐獴 17
會繁衍後代 台灣大學 齊肖琪 Flickr D. Meutia Wiki Mila Zinkova Flickr pixie_bebe 18
會發育成長 Flickr andrewasmith Flickr rouwkema Flickr Aranya Sen (bangalore) 19
會因環境而調適 Flickr Benjamin Pender Flickr Nemo's great uncle 20
生物的恆定現象 調節: 正回饋 負回饋 Flickr Joshua. Davis. Photogr aphy. COM 21
同中有異 Wiki Cook D, Brooks S, Bellone R, Bailey E. 22
核 酸 序 列 細 胞 Wiki user: Mrbean 427 Wiki IP: 69. 226. 103. 13 族 個 群 體 Flickr chrispearson 72 Wiki Mila Zinkova Flickr Guwashi 999 1+1>2 生 態 生命有階層性 27
生物多樣性 細菌 藻類 Flickr INeed. Coffee / Coffee. Hero Wiki NEON/NEON_ja 蕈類 動物 Wiki Jeffrey Schwartz Flickr mikebaird 30
一種魚類病毒鞘蛋白質基因的DNA序列 AGACGTCCATCTCTCAGGTATGTCGAGAATCTCCCAGGCCGTCCTCCCAGCCGGGACAGG AACAGACGGATACGTTGTTGTTGACGCAACCATCGTCCCCGACCTCCTGCCACGACTGGG ACACGCTGCTAGAATCTTCCAGCGATACGCTGTTGAAACACTGGAGTTTGAAATTCAGCC AATGTGCCCCGCAAACACGGGCGGTGGTTACGTTGCTGGCTTCCTGATCCAACTGA CAACGATCACACCTTCGACGCGCTTCAAGCGACTCGTGGTGCAGTCGTTGCCAAATGGTG GGAAAGCAGAACAGTCCGACCACAGTACACCCGTACGCTCCTCTGGACCTCGTCGGGAAA GGAGCAGCGTCTCACGTCACCTGGTCGGCTGATACTCCTGTGTGTCGGCAACAACACTGA TGTGGTCAACGTTTCGGTGCTGTGTCGCTGGAGTGTTCGACTGAGCGTTCCGTCTCTTGA GACACCTGAAGAGACCACCGCTCCCATCATGACACAAGGTCCCCTGTACAACGATTCCCT TTCCACAAACGACTTCAAGTCCATCCTCCTAGGATCCACACCACTGGACATTGCCCCTGA TGGCGCAATCTTCCAGCTGGACCGTCCGCTGTCCATTGATTACAGCCTTGGAACTGGAGA TGTTGACCGTGCTGTCTATTGGCACCTCAAGAAGTATGCTGGAAATACTGGCACACCTGC AGGCTGGTTTCGCTGGGGCATCTGGGACAATTTCAACAAAACGTTCACAG ATGGCGTTGC TTACTACTCTGATGAGCAGCCTCGTCAAATTCTGCTGCCTGTTGGCACTG 40
分子 單股DNA(模板) 轉錄(transcription) 轉譯(translation) 密碼子 蛋白質(protein) 胺基酸(amino acid) 台灣大學 齊肖琪 41
Life is a miracle ! Flickr Zachary. Tirrell 44
版權聲明 作品 授權條件 作者/來源 Flickr D'Arcy Norman http: //www. flickr. com/photos/dnorman/3626610557/ 2010/04/18 visited Flickr ynse http: //www. flickr. com/photos/ynse/542370154/ 2010/04/18 visited Wiki Mariana Ladyof. Hats http: //commons. wikimedia. org/wiki/File: Diagram_cell_nucleus_no_text. svg 2010/04/18 visited Wiki Jypx 3 http: //commons. wikimedia. org/wiki/File: GC_base_pair_jypx 3. png 2010/04/18 visited Wiki Jypx 3 http: //commons. wikimedia. org/wiki/File: AT_base_pair_jypx 3. png 2010/04/18 visited Wiki Cook D, Brooks S, Bellone R, Bailey E. http: //commons. wikimedia. org/wiki/File: Champagne. Kopf. jpg 2010/04/18 visited Flickr thraxil http: //www. flickr. com/photos/41894171126@N 01/71346239 2010/04/18 visited
版權聲明 作品 授權條件 作者/來源 Wiki user: Petwoe http: //commons. wikimedia. org/wiki/File: Fledermaus_rechter_Fluegel-drawing. jpg 2010/04/18 visited Wiki Louisa Howard http: //commons. wikimedia. org/wiki/File: Bronchiolar_epithelium_4_-_SEM. jpg 2010/04/18 visited Wiki Louisa Howard, Michael Binder http: //commons. wikimedia. org/wiki/File: Bronchiolar_area_cilia_crosssections_2. jpg 2010/04/18 visited Wiki E. H. White, Content Provider: Peggy S. Hayes http: //commons. wikimedia. org/wiki/File: Escherichia_coli_flagella_TEM. png 2010/04/18 visited Wiki Magnus Manske http: //commons. wikimedia. org/wiki/File: Gray 9. png 2010/04/18 visited Wiki user: Tronicum http: //commons. wikimedia. org/wiki/File: Sperm-egg. jpg 2010/04/18 visited Wiki Mehregan Javanmard http: //commons. wikimedia. org/wiki/File: Infant_looking_at_shiny_object. jpg 2010/04/18 visited
版權聲明 作品 授權條件 作者/來源 Wiki user: Mrbean 427 http: //commons. wikimedia. org/wiki/File: Dna_segment. JPG 2010/04/18 visited Wiki IP: 69. 226. 103. 13 http: //commons. wikimedia. org/wiki/File: DAPIMito. Tracker. Red. Alexa. Fluor 488 BPAE. j pg/2010/04/18 visited 台灣大學 齊肖琪 Flickr INeed. Coffee / Coffee. Hero http: //www. flickr. com/photos/digitalcolony/2689103249// 2010/04/19 visited Wiki NEON/NEON_ja http: //commons. wikimedia. org/wiki/File: Phytoplankton_Lake_Chuzenji. jpg 2010/04/19 visited Wiki Jeffrey Schwartz http: //commons. wikimedia. org/wiki/File: Frontyard_fungus. jpg 2010/04/19 visited Flickr mikebaird http: //www. flickr. com/photos/mikebaird/397190113/ 2010/04/19 visited
版權聲明 作品 授權條件 作者/來源 Wiki Jjw http: //commons. wikimedia. org/wiki/File: Trophic_dynamics. png 2010/04/19 visited Wiki Lantios http: //commons. wikimedia. org/wiki/File: Horseevolution_Russian. png 2010/04/19 visited Wiki John Gould http: //commons. wikimedia. org/wiki/File: Darwin%27 s_finches. jpeg 2010/4/19 visited 台灣大學 齊肖琪 Flickr adria. richards http: //www. flickr. com/photos/adriarichards/2798736890/ 2010/04/19 visited 台灣大學 齊肖琪
版權聲明 作品 授權條件 作者/來源 Flickr jitze http: //www. flickr. com/photos/jitze 1942/3114723951/ 2010/04/24 visited Wiki Ryan R. Mc. Kenzie http: //commons. wikimedia. org/wiki/File: Labeledstemforposter_copy. jpg 2010/04/24 visited Flickr Tinken http: //www. flickr. com/photos/tinken/99206505/ 2010/4/24 visited Wiki Arnaud Gaillard http: //commons. wikimedia. org/wiki/File: Koala-ag 1. jpg 2010/04/24 visited Flickr robotpolisher http: //www. flickr. com/photos/lintbrush/196788337// 2010/04/24 visited Wiki che http: //commons. wikimedia. org/wiki/File: Dionaea_muscipula_trap. jpg 2010/04/24 visited Flickr D. Meutia http: //www. flickr. com/photos/dewimeutia/2199166062/ 2010/04/24 visited
版權聲明 作品 授權條件 作者/來源 台灣大學 齊肖琪 Wiki Mila Zinkova (user: Mbz 1) http: //commons. wikimedia. org/wiki/File: Mating_Fairy_terns. jpg 2010/04/24 visited Flickr pixie_bebe http: //www. flickr. com/photos/pixie_bebe/30335860/ 2010/4/24 visited Flickr andrewasmith http: //www. flickr. com/photos/andrewasmith/4395999496/ 2010/04/24 visited Flickr Aranya Sen (bangalore) http: //www. flickr. com/photos/aranyasen/1558676713/ 2010/04/24 visited Flickr rouwkema http: //www. flickr. com/photos/rouwkema/3708858511/ 2010/04/24 visited Flickr Benjamin Pender http: //www. flickr. com/photos/benpender/480494623/in/set-72057594137006971/ 2010/04/24 visited
版權聲明 作品 授權條件 作者/來源 Flickr Nemo’s great uncle http: //www. flickr. com/photos/maynard/4007569323/ 2010/04/24 visited Flickr Joshua. Davis. Photogr aphy. COM http: //www. flickr. com/photos/articnomad/180092696/ 2010/04/24 visited Flickr Guwashi 999 http: //www. flickr. com/photos/guwashi 999/3378522703// 2010/4/24 visited Flickr chrispearson 72 http: //www. flickr. com/photos/53175227@N 00/2376592289/ 2010/04/24 visited Wiki Mila Zinkova (user: Mbz 1) http: //commons. wikimedia. org/wiki/File: King_Penguins_at_South_Georgia_Island. j pg/2010/04/24 visited Flickr Zachary. Tirrell http: //www. flickr. com/photos/tirrell/149037977/ 2010/04/24 visited 台灣大學 齊肖琪